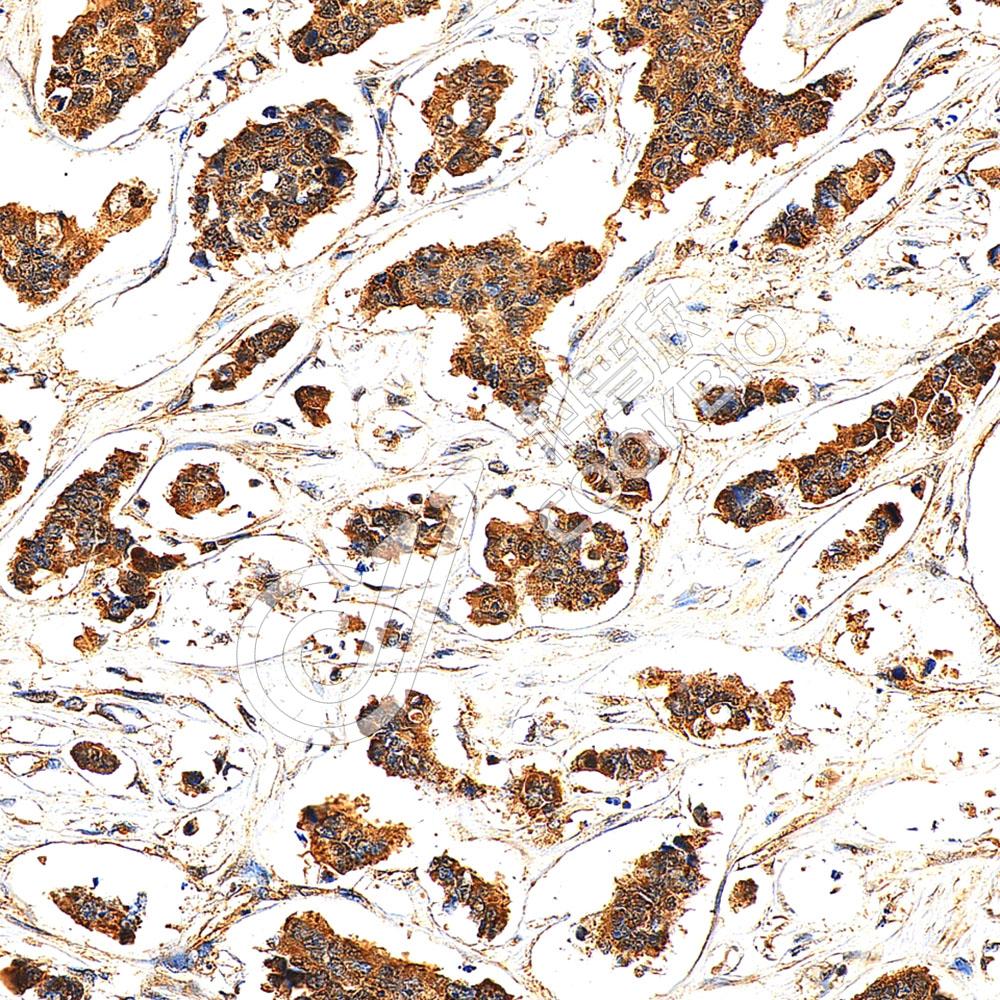

抗体筛选:
抗体筛选:
-
Anti-CK1 epsilon 兔多克隆抗体Wnt通路货号:K1333699-100 规格:100 μL ¥ 1900比较查看详情
-
Anti-NDRG2 兔多克隆抗体 兔多抗原癌/抑癌基因蛋白,神经发育,Wnt通路货号:K1335499-100 规格:100 μL ¥ 1900比较查看详情
-
Anti-LGR5 兔多克隆抗体Wnt通路,G蛋白偶联受体货号:K1336054-100 规格:100 μL ¥ 1900比较查看详情
-
Anti-NDP 兔多克隆抗体 兔多抗Wnt通路货号:K1337926-100 规格:100 μL ¥ 1900比较查看详情
-
Anti-Dishevelled 3 兔多克隆抗体 兔多抗Wnt通路货号:K1339696-100 规格:100 μL ¥ 1900比较查看详情
-
Anti-CSRP1 兔多克隆抗体 兔多抗Wnt通路货号:K1341106-100 规格:100 μL ¥ 1900比较查看详情
-
Anti-APCDD1 兔多克隆抗体 兔多抗Wnt通路货号:K1343560-100 规格:100 μL ¥ 1900比较查看详情
-
Anti-SFRP5 兔多克隆抗体 兔多抗Wnt通路货号:K1343938-100 规格:100 μL ¥ 1900比较查看详情
-
Anti-CCDC88C 兔多克隆抗体 兔多抗Wnt通路货号:K1345927-100 规格:100 μL ¥ 1900比较查看详情
-
Anti-LGR5 兔多克隆抗体 兔多抗Wnt通路,G蛋白偶联受体货号:K1346599-100 规格:100 μL ¥ 1900比较查看详情
需要技术支持?
如果您有任何问题或如果您在实验过程中遇到问题,或需要更详细的技术指导,请联系我们的技术支持团队
 400-6027-270
400-6027-270
联系我们
如果您对我们的公司或产品有任何疑问,欢迎随时联系我们

湖北省武汉市东湖新技术开发区高新二路388号生物医药加速器22栋5楼
湖北省武汉市东湖新技术开发区高新二路388号生物医药加速器22栋5楼  400-6027-270
400-6027-270  鄂公网安备42018502008544号
鄂公网安备42018502008544号